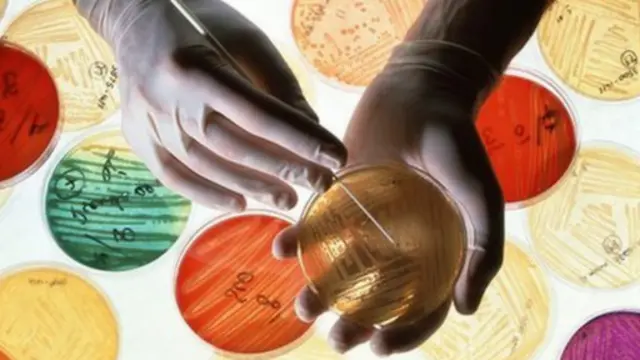
antibiotik

Kebal antibiotik ancaman kesehatan dunia
Organisasi Kesehatan Dunia, WHO memperingatkan bahwa kekebalan terhadap antibiotik menjadi ancaman global bagi kesehatan masyarakat.
Badan dunia ini menganalisa data dari 114 negara dan mengatakan kekebalan antibiotik terjadi "di hampir setiap wilayah di dunia."
WHO mengatakan bahwa dunia menuju era di mana manusia dapat meninggal karena infeksi biasa dan luka-luka ringan karena beberapa obat-obatan utama tidak dapat lagi menyembuhkan.
Organisasi dunia ini menunjuk pemberian resep obat berlebihan dan penyalahgunaan antibiotik yang mempercepat penyebaran bakteri super.
Laporan WHO dipusatkan pada tujuh bakteri yang dianggap menyebabkan penyakit parah seperti pneumonia, diare dan infeksi darah.
Disebutkan pula bahwa dua antibiotik utama tidak lagi ampuh pada lebih dari setengah jumlah orang yang dirawat di sejumlah negara.
WHO juga mengatakan antibiotik baru perlu segera dikembangkan, dengan sistem pengawasan penggunaan yang lebih baik.
Dalam laporannya, WHO mengatakan kekebalan antibiotik misalnya termasuk untuk infeksi saluran kencing akibat E.coli misalnya yang menjadi tidak efektif dalam lebih setengah kasus dewasa ini.









